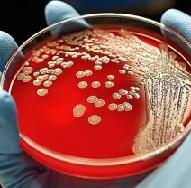
бак посев мочи расшифровка
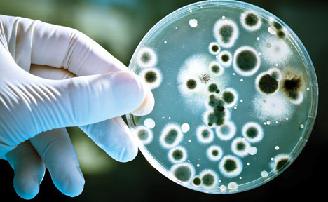
бак посев мочи

Врачи могут назначать бакпосев мочи как пациентам, которые были инфицированы недавно, так и пациентам с рецидивирующим течением болезни.
Основным минусом метода является его чрезмерная длительность и повышенные требования к забору материала. Однако при этом бактериологический посев мочи позволяет врачу получить уникальные данные, которые не определяются ни одним другим исследованием.
Что такое бак посев, и для чего он нужен?
Бак посев – анализ мочи, который подразумевает под собой использование ее, как лабораторного материала для того, чтобы вырастить бактерии в моче. Проводится исследование при определенной температуре и с соблюдением медицинских стандартов и норм.
Назначается данный вид исследования для того, чтобы определить, какие именно микробы находятся в том очаге, откуда брался для исследования материал, а также установить, есть ли болезнетворные микробы и какое их количество.
Бак посев на флору и чувствительность к антибиотикам дает возможность определить и то, к каким именно лекарственным препаратам микробы имеют чувствительность, благодаря чему появляется возможность провести максимально эффективное лечение.
Врачи подчеркивают важность правильной подготовки к анализу мочи на бактериальный посев. Для получения достоверных результатов необходимо соблюдать несколько простых рекомендаций. Специалисты советуют собирать утреннюю порцию мочи, так как она наиболее концентрированная. Перед сбором анализа следует провести гигиенические процедуры, чтобы избежать загрязнения образца. Важно также избегать приема антибиотиков за несколько дней до теста, так как они могут исказить результаты.
Анализ мочи на бак посев позволяет выявить наличие бактерий и определить их чувствительность к антибиотикам, что помогает врачам назначить эффективное лечение инфекций мочевыводящих путей. Врачи отмечают, что данный анализ является важным инструментом в диагностике, позволяющим не только подтвердить инфекцию, но и исключить другие заболевания. Правильная сдача анализа способствует более точной интерпретации результатов и, как следствие, успешному лечению пациента.
https://youtube.com/watch?v=VdMeuw2Ps0Y
Как правильно собрать мочу на бак посев?
Накануне такой процедуры настоятельно рекомендуется отказаться от потребления овощей, а также фруктов, которые способны поменять окраску мочи. К таковым относят морковку, свеклу и некоторые другие. Также нельзя пить любые мочегонные препараты. Подобные исследования не стоит проводить женщинам на этапе менструации.
Чтобы защитить пробу мочи от микроорганизмов, которые находятся на слизистой следует выполнить определенные правила:
- Материал для анализа должен собираться только в стерильную емкость, понадобится примерно половина утренней урины, при этом первая порция должна пойти в унитаз, а остальное – в контейнер. Заранее надо будет провести гигиену наружных половых органов.
- Чтобы получить максимально точный результат, собранная для анализа моча, должна быть сдана в лабораторию не позже часа, после сбора.
Примерно спустя три недели, после завершения приема назначенных лекарственных препаратов, пациенту рекомендуется повторно сдать бак посев мочи, чтобы определить насколько эффективным оказалось лечение.
Цена и сроки
Многие люди интересуются, сколько дней делается анализ на бак посев. Однозначно на этот вопрос ответить нельзя, все зависит от того, какой материал подвергается исследованию и какой возбудитель нужно искать. Иногда ответ готов через 3 дня, иногда через 1-2 недели, поскольку некоторые образцы требуют пересева на другую среду.
Примерная стоимость этого анализа мочи в Москве составляет порядка 800 – 1500 рублей.
Анализ мочи на бактериальный посев — это важный диагностический метод, который помогает выявить инфекции мочевыводящих путей. Многие пациенты отмечают, что процедура сбора мочи достаточно проста, но требует соблюдения определенных правил. Важно использовать стерильный контейнер и собирать среднюю порцию мочи, чтобы избежать загрязнения. Результаты анализа могут показать наличие патогенных микроорганизмов, их количество и чувствительность к антибиотикам, что помогает врачам назначить эффективное лечение. Люди также подчеркивают, что анализ может занять несколько дней, но это время оправдано, так как позволяет точно определить причину заболевания. В целом, анализ мочи на бак посев считается надежным способом диагностики и играет ключевую роль в лечении инфекций.
https://youtube.com/watch?v=gCy85h8TF7w
Расшифровка анализа бакпосева мочи
КОЕ – это одна микробная клетка (или группа). В этих единицах характеризуется развитие колонии микроорганизмов. Например, показатели в 1000 КОЕ/мл говорят о том, что микроорганизмы случайно попали в заборный материал с наружных половых органов. В этом случае лечить ничего не надо.
Когда же лабораторное исследование превышает концентрацию 100 000 КОЕ/мл, то можно говорить о связи воспаления именно с инфекцией. При промежуточном результате 1000-10 000 КОЕ/мл анализ мочи на бакпосев вызывает сомнения, и требуется повторное исследование.
При положительном анализе в заключении перечисляются обнаруженные микроорганизмы: бактерии, грибы, простейшие и т.д. После окончательной расшифровки бактериологического посева мочи назначаются как дополнительные анализы, так и окончательный курс лечения.
Бак посев мочи при беременности
Анализ мочи на бак посев при беременности проводится, как правило, дважды: первый – при постановке на учет по беременности, второй – практически перед самым процессом родоразрешения, на 36 неделе.
В тех случаях, когда при расшифровке общего анализа мочи в результате были обнаружены лейкоциты или белок, анализ мочи на бак посев может проводиться и чаще, с целью установления чувствительности патогенных микроорганизмов к назначаемым антибактериальным лекарственным средствам. Кроме того, в случае, если проводится лечение урологических инфекций подобное исследование проводится спустя 7 дней после отмены прописанных антибиотиков.
Чтобы правильно сдать мочу на бак посев необходимо:
- Приобрести стерильную ёмкость и собрать в неё первую утреннюю мочу, предварительно тщательно подмывшись.
- Когда биоматериал отобран, нужно тщательно закрыть контейнер крышкой и отнести пробу в лабораторию на исследование как можно быстрее, желательно в течение 2 часов.
В независимости от цены данного анализа, вам обязательно нужно его проводить для того, чтобы предотвратить возможные болезни, сохранить беременность, не навредить плоду и предотвратить болезни, которые в будущем могут обойтись не только дороже, но и сложнее в лечении.
https://youtube.com/watch?v=qCYLt_ZMlmY
Вопрос-ответ
Как правильно подготовиться к сдаче анализа мочи на бакпосев?
Для правильной подготовки к анализу рекомендуется избегать употребления антибиотиков за 48 часов до сдачи анализа, а также не пить алкоголь и не есть острые блюда. Важно также обеспечить чистоту половых органов перед сбором мочи, чтобы избежать загрязнения образца.
Какой объем мочи необходим для анализа и как ее собирать?
Для бакпосева обычно требуется около 50-100 мл свежесобранной мочи. Моча должна быть собрана в стерильный контейнер. Рекомендуется использовать среднюю порцию мочи: сначала немного помочиться в унитаз, затем собрать мочу в контейнер и закончить мочеиспускание в унитаз.
Что может показать анализ мочи на бакпосев?
Анализ мочи на бакпосев позволяет выявить наличие бактерий, грибков и других микроорганизмов в моче, а также определить их чувствительность к антибиотикам. Это помогает в диагностике инфекций мочевыводящих путей и выборе эффективного лечения.
Советы
СОВЕТ №1
Перед сдачей анализа мочи на бактериальный посев, рекомендуется избегать употребления антибиотиков за 48-72 часа до процедуры. Это поможет получить более точные результаты, так как антибиотики могут подавлять рост бактерий в образце.
СОВЕТ №2
Для получения достоверных результатов важно правильно собрать мочу. Используйте стерильный контейнер и следуйте правилам сбора: начните с чистоты половых органов, соберите среднюю порцию мочи, избегая контакта с кожей.
СОВЕТ №3
Не забывайте, что некоторые продукты и лекарства могут влиять на результаты анализа. Например, свекла может окрасить мочу, а витамины группы B — изменить её цвет и запах. Убедитесь, что ваш врач знает о всех принимаемых вами препаратах и добавках.
СОВЕТ №4
После получения результатов анализа, обязательно обсудите их с врачом. Он поможет интерпретировать данные и назначить необходимое лечение, если это потребуется. Не стоит заниматься самодиагностикой и самолечением.